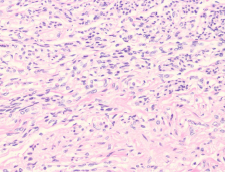

Spotřební materiál

Histologické kazety Epredia
Katalogové číslo: B851...

Diamond Point Marker
Katalogové číslo: 750

Parafín
Katalogové číslo:

Parapel™ Paraffin Repelent
Katalogové číslo: 2300

Base Mold Release
Katalogové číslo: 6600

HistoGel
Katalogové číslo: HG-4000-012
Thermo Scientific Richard Allan Scientific HistoGel je kompozitum vodního gelu vhodné pro zpracování histologických a cytologických vzorků.

Shandon CytoRich Red Collection Fluid
Katalogové číslo: B99908...

Richard-Allan Scientific Resolve Immersion Oil
Katalogové číslo: M...
Vytac
Katalogové číslo: 540...

Specimen Stages
Katalogové číslo: 715...

Richard-Allan Scientific Mark-It Tissue Marking Dyes
Katalogové číslo: 5000

Shandon Tissue Marking Dyes
Katalogové číslo: 3120123

Biopsy Bags - Blue
Katalogové číslo: 67740...

Biopsy Bags - White
Katalogové číslo: 67740...

Biopsy Bags - White
Katalogové číslo: 677405...

Parapel™ Paraffin Repelent
Katalogové číslo: 2300

Liter Reagents – Syntri Safeguard
Katalogové číslo: ...SS

Neutral Buffered Formalin 10%
Katalogové číslo: 57...

Formaldehyde 37%
Katalogové číslo: 9311

Zinc Formalin 10%
Katalogové číslo: 570...

Zinc Formalin, Unbuffered 10%
Katalogové číslo: 7600

Signature Series Pen-Fix
Katalogové číslo: 61---
Bouin’s Fluid
Katalogové číslo: 57211

Shandon Glyo-Fixx
Katalogové číslo: 676.../999...

Shandon Formal-Fixx
Katalogové číslo: 676.../999...

Shandon Zinc Formal-Fixx
Katalogové číslo: 676.../999:::
Shandon Rapid-Fixx Formalin
Katalogové číslo: 6764212

Richard-Allan Scientific Mucolytic Agent
Katalogové číslo: 76166 / 76167

Richard-Allan Scientific Saccomanno Fluid
Katalogové číslo: 76160 / 76161

Richard-Allan Scientific Fix-Rite 2
Katalogové číslo: 76150

Shandon Cytospin Collection Fluid
Katalogové číslo: 6768... / 9990...

Shandon Mucolexx
Katalogové číslo: 999037...

Liter Reagents – Syntri Safeguard
Katalogové číslo: ...5SS
Vytac
Katalogové číslo: 540...
Cal-Rite
Katalogové číslo: 5501 / 5525
Decalcifying Solution
Katalogové číslo: 8340 / 8340-1

Shandon TBD-1 Decalcifier
Katalogové číslo: 6764001 / 6764002

Shandon TBD-2 Decalcifier
Katalogové číslo: 6764003 / 6764004

Richard-Allan Scientific Signature Series Flex 100, 95, 80
Katalogové číslo: 8...

Richard-Allan Scientific Dehydrant 100%, 95%, 80%, 70%
Katalogové číslo: 6... / 7...

Liter Reagents – Syntri Safeguard
Katalogové číslo: ...SS

Richard-Allan Scientific Signature Series Clear-Rite 3
Katalogové číslo: 6901 / 6915

Shandon Xylene Substitute
Katalogové číslo: 676.../999...
Citrus Clearing Solvent
Katalogové číslo: 8301

Richard-Allan Scientific Xylene
Katalogové číslo: 6601 / 6615
Richard-Allan Scientific Toluene
Katalogové číslo: 9715

Liter Reagents – Syntri Safeguard
Katalogové číslo: ...SS

Micro-Cassette
Katalogové číslo: 33124

Disposable Base Molds
Katalogové číslo:

Stainless Steel Base Molds
Katalogové číslo: 640...

Peel-A-Way™ Disposable Embedding Molds
Katalogové číslo: 1... / 2...

Histologické kazety Epredia
Katalogové číslo: B851...

MX35 Ultra™ Low-Profile Blade
Katalogové číslo: 3053835

MX35 Premier +™ Low-Profile Blade
Katalogové číslo: 3052835

MX35 Premier™ Low-Profile Blade
Katalogové číslo: 3051835

MB35™ Premier Low-Profile Blade
Katalogové číslo: 3050835

MB22 Premier™ Low-Profile Blade
Katalogové číslo: 3050822

HP35 Ultra™ High-Profile Blade
Katalogové číslo: 3153735

HP35TM High-Profile Blade
Katalogové číslo: 3150734

Reusable Steel Knives
Katalogové číslo: 152020 / 152120

Reusable Steel Knives
Katalogové číslo:
Terčíky ke kryostatu
Katalogové číslo: 715...

Shandon CryomatrixTM Embedding Medium
Katalogové číslo: 6769006

Shandon M-1 Embedding Matrix
Katalogové číslo: 1310

Cryochrome
Katalogové číslo: 999042...

Neg-50 Frozen Section Medium
Katalogové číslo: 650...

Richard-Allan Scientific Hematoxylin
Katalogové číslo: 7211 / 7211L

Richard-Allan Scientific Hematoxylin
Katalogové číslo: 7212 / 7212L

Richard-Allan Scientific Hematoxylin 1
Katalogové číslo: 7221 / 7221L

Richard-Allan Scientific Hematoxylin 2
Katalogové číslo: 7231

Richard-Allan Scientific Eosin-Y
Katalogové číslo: 7111 / 7111L

Richard-Allan Scientific Bluing Reagent
Katalogové číslo: 73...

Richard-Allan Scientific Clarifier 1, 2
Katalogové číslo: 74...

Richard-Allan Scientific Gill 1, 2, 3 Hematoxylin
Katalogové číslo: 72...

Richard-Allan Scientific Modified Harris Hematoxylin
Katalogové číslo: 72704 / 72711

Richard-Allan Scientific Modified Mayer’s Hematoxylin
Katalogové číslo: 72804

Richard-Allan Scientific Differentiating Solution
Katalogové číslo: 74204 / 74211

Richard-Allan Scientific Eosin-Y Alcoholic, Eosin-Y with Phloxine, Eosin-Y Saturated
Katalogové číslo: 71...

Shandon Harris Hematoxylin
Katalogové číslo: 676500...

Shandon Instant Hematoxylin
Katalogové číslo: 6765015

Shandon Gill Hematoxylin 1, 2, 3
Katalogové číslo: 676500...

Shandon Bluing Reagent
Katalogové číslo: 6769001 / 6769002

Shandon Nu-Clear
Katalogové číslo: 6769008 / 6769009

Shandon Eosin-Y
Katalogové číslo: 67660...
Shandon Instant Eosin
Katalogové číslo: 6765040 / 6765540

Richard-Allan Scientific Acid-Fast Bacillus Stain (Green Secondary Stains)
Katalogové číslo: 87015

Richard-Allan Scientific Acid-Fast Bacillus Stain (Blue Secondary Stains)
Katalogové číslo: 87016

Richard-Allan Scientific Amyloid Stain
Katalogové číslo: 87003

Richard-Allan Scientific Methyl Green-Pyronin Y
Katalogové číslo: 87011

Richard-Allan Scientific Iron Stain
Katalogové číslo: 87006

Richard-Allan Scientific Elastic Stain
Katalogové číslo: 87017

Richard-Allan Scientific Gram Stain (Tissue)
Katalogové číslo: 87017

Richard-Allan Scientific Periodic Acid-Schiff (PAS)
Katalogové číslo: 87007

Richard-Allan Scientific Modified Grocott’s Methenamine Silver (Chromic Acid)
Katalogové číslo: 87024

Richard-Allan Scientific Modified Grocott’s Methenamine Silver (Periodic Acid)
Katalogové číslo: 87008

Richard-Allan Scientific Alcian Blue/PAS
Katalogové číslo: 87023

Richard-Allan Scientific Reticulin Silver
Katalogové číslo: 87025

Richard-Allan Scientific Steiner-Steiner Silver
Katalogové číslo: 87009

Richard-Allan Scientific Masson Trichrome
Katalogové číslo: 87019

Richard-Allan Scientific Mucicarmine
Katalogové číslo: 87012

Shandon Periodic Acid Schiff Kit (PAS)
Katalogové číslo: B24200-250

Richard-Allan Scientific Wright Stain
Katalogové číslo: 8901...

Richard-Allan Scientific Buffered Wright Stain
Katalogové číslo: 3111

Richard-Allan Scientific Wright-Giemsa Stain
Katalogové číslo: 8901...

Richard-Allan Scientific Buffered Wright-Giemsa Stain
Katalogové číslo: 3121

Richard-Allan Scientific May-Grunwald Stain
Katalogové číslo: 89027

Richard-Allan Scientific Reticulocyte Stain
Katalogové číslo: 89029

Richard-Allan Scientific Jenner Stain
Katalogové číslo: 89030

Richard-Allan Scientific Three-Step Stain
Katalogové číslo: 3300

Richard-Allan Scientific Phosphate Buffer (6.6, 7.2)
Katalogové číslo: 89032 / 89033

Shandon Kwik-Diff Stains
Katalogové číslo:

Richard-Allan Scientific Gram Stain Kit (Film)
Katalogové číslo: 87101

Shandon Gram Stain
Katalogové číslo: 9990721 / 9990725

Shandon Rapid-Chrome Papanicolaou Staining Kit
Katalogové číslo: 9990020

Shandon Rapid-Chrome H&E Frozen Section Staining Kit
Katalogové číslo: 9990001

Shandon Rapid-Chrome Kwik-Diff Staining Kit
Katalogové číslo: 9990702

Richard-Allan Gomoris Trichrome (Blue Collagen)
Katalogové číslo: 87021

Richard-Allan Scientific Papanicolaou Stain EA
Katalogové číslo: 75...

Shandon EA-50 Stain
Katalogové číslo: 6766001/6766002

Shandon EA-65 Stain
Katalogové číslo: 6766003/6766004

Shandon OG-6 Stain
Katalogové číslo: 6766005/6766006

ClearVue Coverslip Hoppers
Katalogové číslo: A79210...

Coverglass Thumb Forceps
Katalogové číslo: 19040

Kuehne Coverglass Thumb Forceps
Katalogové číslo: 19060

Richard-Allan Scientific Resolve Immersion Oil
Katalogové číslo: M...

Signature Series Mounting Medium
Katalogové číslo: 4112 / 4111

ClearVue-Approved Mounting Mediums
Katalogové číslo: 4211 / 4212

Cytoseal 60 and 280
Katalogové číslo: 831...

Cytoseal XYL
Katalogové číslo: 8312-4

Shandon-Mount
Katalogové číslo: 190033.../ 9990435

Shandon Immu-Mount
Katalogové číslo: 99904...

Shandon Xylene Substitute Mountant
Katalogové číslo: 190023... / 9999122

EZ-Mount
Katalogové číslo: 9999120

Shandon Synthetic Mountant
Katalogové číslo: 6769007

Shandon EZ Single Cytofunnel with White Filter Cards
Katalogové číslo: A78710003/A78710020

Shandon EZ Single Cytofunnel with Brown Filter Cards
Katalogové číslo: A78710004

Shandon EZ Double Cytofunnel
Katalogové číslo: A78710005 / A78710021

Shandon EZ Megafunnel with Cap and Slide
Katalogové číslo: A78710001

Shandon Single Cytofunnel with White Filter Cards
Katalogové číslo: 5991040 / 1102548

Shandon Single Cytofunnel with Brown Filter Cards
Katalogové číslo: 5991043

Shandon Double Cytofunnel
Katalogové číslo: 5991039 / 1102547

Shandon Cytoclip Stainless Steel Slide Clip
Katalogové číslo: 59910052

Shandon TPX Single Sample Chamber, Caps, and Filter Cards
Katalogové číslo: A78710018 / 59910025

Filter cards
Katalogové číslo: 5991023 / 5991022

Shandon Octospot
Katalogové číslo: 10016...

Shandon Cytoblock Cell Block Preparation System
Katalogové číslo: 7401150 / 7401151

Shandon Cell-Fixx Spray Adhesive
Katalogové číslo: 6768326

Diamond Point Marker
Katalogové číslo: 750
Specimen and Grossing Containers
Katalogové číslo:

Saws, Virchow skull breaker
Katalogové číslo:

Forceps and Scissors
Katalogové číslo:

Boards
Katalogové číslo:






